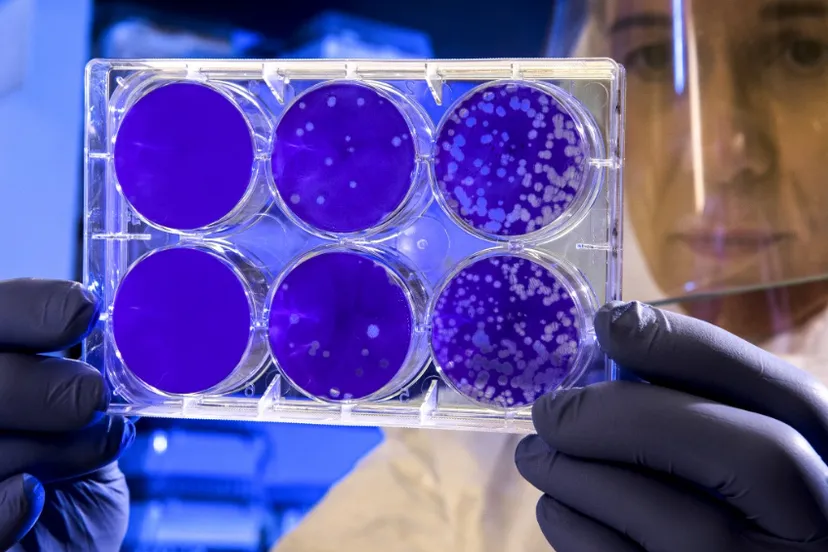
screenshot 20201018 151713

Vuurwerk kwijt na opblazen putdeksel
19 okt 2020, 6:32 • 112

Politie Zaanstreek
Een met vuurwerk opgeblazen putdeksel krijgt voor een jonge Zaankanter nog een staartje. Hij mag zich melden op het bureau en is zijn voorraad kwijt.
Gisteren werd de politie gebeld nadat een putdeksel met een flinke knal de lucht in ging en ter plekke werd het adres van één van de vermoedelijke daders achterhaald. Agenten gingen op onderzoek uit en vonden bij hem thuis een verzameling knallers (zie de foto hierboven), die in beslag is genomen. De jongeman mag op een later moment langskomen voor verhoor op het politiebureau.
Loading articles...
Loading